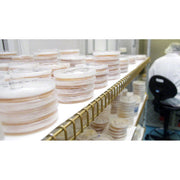

An elastic, wax-like film that can be stretched to seal petri dishes and test tubes. Measures 2 inches by 250 feet. Many cultivators wrap individual culture dishes, once inoculated, to prevent the entry of contaminants along the periphery. We highly recommend this procedure for beginners and for anyone who frequently experiences the havoc wreaked by airborne contaminants.
An elastic, wax-like film that can be stretched to seal petri dishes and test tubes. Measures 2 inches by 250 feet. Many cultivators wrap individual culture dishes, once inoculated, to prevent the entry of contaminants along the periphery. We highly recommend this procedure for beginners and for anyone who frequently experiences the havoc wreaked by airborne contaminants.